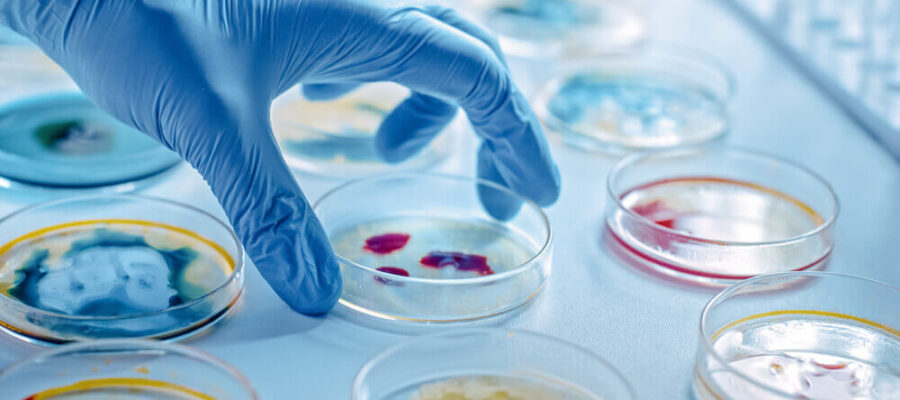
Mikrobiyoloji

Mikrobiyoloji-Viroloji
BACTEC yönetimi ile tüberküloz basili tayini
Direkt ARB
Gonokok direkt
Kalın damla
Kan grubu
PPD
Dışkıda parazit aranması
Nazal Smear
Monotest
Step A
Rotavirüs
Gebelik testi
Kültür antibiogram (kan, boğaz, gaita,
üretral akıntı, mantar, pü göz akıntısı,
vajen, burun akıntısı, idrar, balgam,
plevra mayii, kulak akıntısı, asit mayii)
Bakteri
Brucella (IgM/IgG)
Brucella Wright
Borrelia burgdorferi (IgM/IgG)
Bordetella pertussis (IgM/IgG)
Camphylobacter jejuni (IgG)
Chlamydia travhomatis (IgG/IgM)
Chlamydia psittaci (IgG/IgM)
Helicobacter pylori IgG
Listeria
Leptospira IgG
Mycoplasma pneumonriae
Mycobacterium tuberculosis
Neisseria gonorrhoeae
Rickettsia IgG
Salmonella
Salmonella (Gruber-Widal)
Shigella IgG
Streptococcus pneumoniae
Toxoplasma (IgG/IgM)
Yersinia (IgG/IgM)
Vibrio cholerae
Sexüel Enfeksiyon
Gonokok antijen
Chlamydia antijen
Ureaplasma urealyticum
Gardnerella
Mycoplasma
Parazit
Ascaris
Candida albicans
Echinococcus (IHA)
Entamoeba histolytica
Leishmania
Malaria
Thichomonas
Toxoplasma gondii,
Toxoplasma gondii,
Trypanosoma
Virüs
Adenovirüs IgG
Bunyavirüs
CMV IgG-IgM
Coxsackie B1
Coxsackie B6
Coxsackie A
Denguevirus Antikor
EBV
EBV-VCA (IgM-IgG)
EBV-EA
ECHO
FSME
Hantavirüs
HSV 1 IgG-IgM
HSV 2IgG-IgM
Influenza A
Influenza B
Masern (IgM-IgG)
Mumps (IgM-IgG)
Parvovirüs B 19
Polio
Pikornavirüs
Rubella (IgG-IgM)
Rotavirüs
Varicella Zoster


